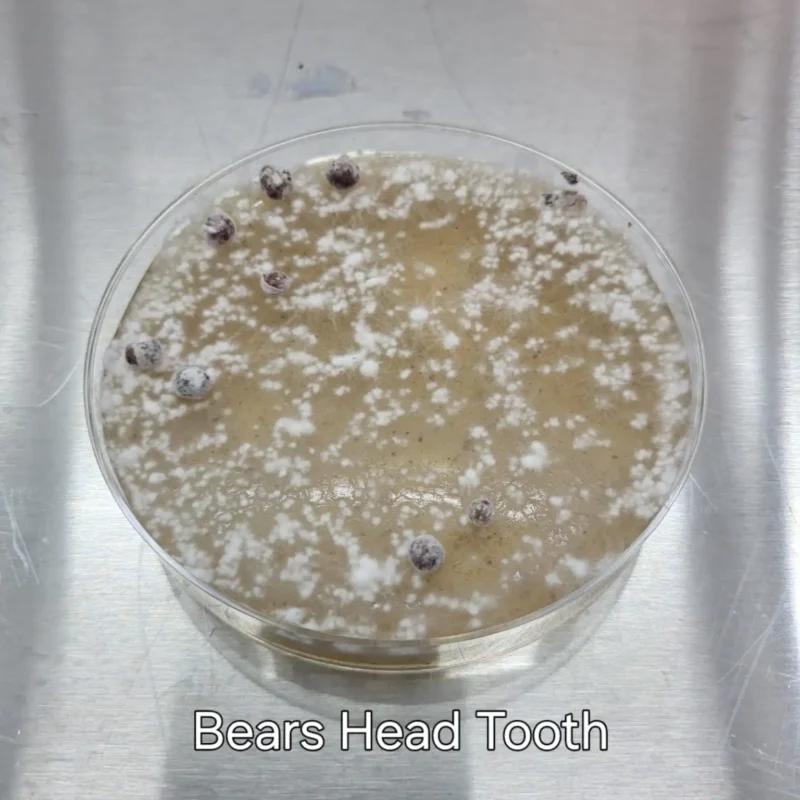
Mushroom Culture Plates

-
Mushroom Culture Plates
1 Product -

Bag & Spawn Subscriptions
12 Products -

Mushroom Filter Patch Bags
18 Products -

Mushroom Products
5 Products -

Colonized Grain Spawn
5 Products -

Sterilized Grain & Sterilized Substrate
8 Products -

Equipment
43 Products -

Impulse Sealers
10 Products -

Flow Hoods & HEPAÂ Filters
13 Products -

Sterilizers and Pressure Cookers
5 Products
Mushroom Cultivation Classes
Aside from providing high‑quality products, Eric also offers two‑day hands‑on mushroom cultivation classes. This is designed to help those who are interested in learning how to grow mushrooms for profit. He focuses on teaching the significance of having proper design, layout, and equipment in producing mushrooms. He offers small classes with only six students. Register now to have a slot!
Mushroom Consultant
Eric Myers conducts phone and video consultations for commercial mushroom cultivation. You can rely on him to provide advice with his experience constructing and operating four successful mushroom farms from 300 to 3,000 sq/ft. He has offered his services to more than 100 successful farmers since 2017 and is ready to help you achieve your goals!
Buy My Recommended Equipment on
Kit.com/MyersMushrooms Is the one stop shop for a mushroom farmer. Get all your cultivation supplies! As an Amazon Associate I earn from qualifying purchases through my kit website links.
Get Mentoring and Advice on
Get access to patron only content and info, receive one on one mentoring.
Custom Mushroom Sterilizers
Designed by yours truly these mushroom sterilizers are the best value on the market for atmospheric sterilization.
Mission Statement
Myers Mushrooms is focused on spreading the skills and knowledge of commercial mushroom growing. His goal is to help you start producing gourmet mushrooms for profit!
Products
Myers Mushroom LLC offers mushroom equipment, supplies, and training for both hobby and professional mushroom growers. We work with top suppliers and manufacturers within the USA. Most of our products are custom manufactured specifically for the mushroom growing community.